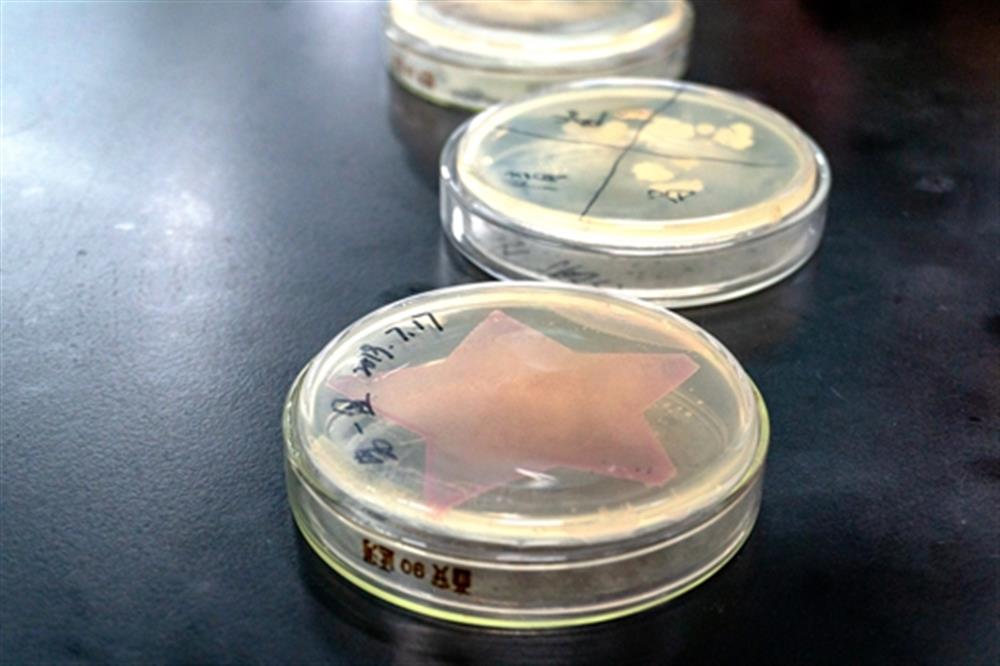
同学们做好的培养皿

培养皿制作

湖北省第一届微生物培养皿艺术设计大赛举行
图片尺寸4096x2730
生物艺术|培养皿09上制作"微观世界"_艺术_培养皿_艺术家_anker怎么
图片尺寸1080x720
生物艺术|培养皿09上制作"微观世界"_艺术_培养皿_艺术家_anker怎么
图片尺寸1080x720
生物艺术|培养皿09上制作"微观世界"_艺术_培养皿_艺术家_anker怎么
图片尺寸1080x1439
学校第二届微生物培养皿艺术设计大赛结束
图片尺寸700x467
每个培养皿中加入15ml~20ml的琼脂培养基后混合均匀,待琼脂凝固后, 将
图片尺寸1080x744
商品分类 商品材质 手工制作 台湾出品 原创商品 |香香的干燥花培养皿
图片尺寸500x500
儿童diy手工科学实验益智科学小制作幼教 植物培养皿科教玩具
图片尺寸800x800
看看这美如画的培养皿,还敢说科学家不懂艺术和创意?
图片尺寸600x544
平板培养皿的制作
图片尺寸1152x720
长春中医药大学首届微生物培养皿艺术大赛圆满结束
图片尺寸568x567
【培养皿艺术大赛ing 】高校,科研院所作品欣赏(部分)
图片尺寸735x244
生物艺术|培养皿09上制作"微观世界"_艺术_培养皿_艺术家_anker怎么
图片尺寸1080x1439
制作材料:大肠杆菌,emp培养基创意描述:马踏飞燕是东汉艺术家的经典之
图片尺寸600x507
资料图:培养皿中的"超级真菌".
图片尺寸1080x721
图为实践队员正在将样品均液加入培养皿中.jpg
图片尺寸600x400
培养皿里生长的微生物
图片尺寸1890x1620
科学家用培养皿制作出人类大脑还让它长出眼睛细思极恐
图片尺寸641x433
试管 针管 培养皿能制作奶茶你试过没?小姐妹们快来一起"搞"一杯!
图片尺寸1000x737
同学们做好的培养皿
图片尺寸1000x666